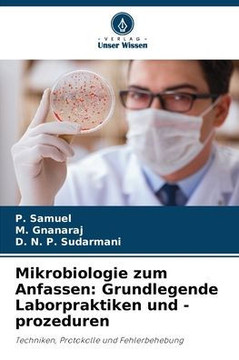
Mikrobiologie zum Anfassen: Grundlegende Laborpraktiken und -prozeduren

Dieses Werk enth?lt die neue Lehre des "Dimensionismus" - ein Buch, welches den Menschen den Weg ins "neue goldene Zeitalter" ebnen und vereinfachen soll. Es befasst sich mit der Entstehungsgeschichte unseres Universums, des Lebens im Weltall sowie auf der Erde. Ebenso werden detailliert die Menschen und ihre besondere Rolle im "Sch?pfungsplan" betrachtet.
| Author: Oliver Jung |
| Publisher: Librius Verlag |
| Publication Date: Oct 10, 2009 |
| Number of Pages: 106 pages |
| Binding: Paperback or Softback |
| ISBN-10: 3940404160 |
| ISBN-13: 9783940404169 |